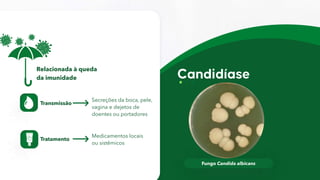
Fungo Candida albicans
Transmissão
Secreções da boca, pele,
vagina e dejetos de
doentes ou portadores
Tratamento
Medicamentos locais
ou sistêmicos
Relacionada à queda
da imunidade

O documento discute vários agentes causadores de doenças sexualmente transmissíveis, incluindo bactérias, fungos, vírus e protozoários. Detalha os sintomas, mecanismos de transmissão e tratamentos de doenças como sífilis, gonorreia, herpes, HIV/AIDS, candidíase e crabs.